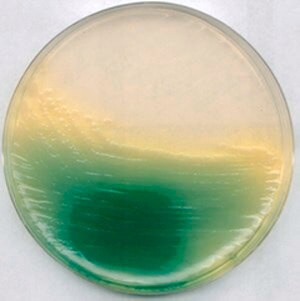
Merck King Agar BNutriSelect Basic

Merck King Agar BNutriSelect Basic
상품 한눈에 보기
King Agar BNutriSelect Basic은 미생물 배양용 영양 한천 배지입니다. 고품질의 성분으로 안정적인 배양 결과를 제공합니다. Merck Sigma의 신뢰성 있는 연구용 시약으로 다양한 미생물학 연구에 적합합니다.
브랜드: Merck Sigma
✨AI 추천 연관 상품
AI가 분석한 이 상품과 연관된 추천 상품들을 확인해보세요
연관 상품을 찾고 있습니다...
Merck King Agar BNutriSelect Basic
Merck Sigma의 King Agar BNutriSelect Basic은 미생물 배양을 위한 기본 영양 한천 배지로, 안정적이고 재현성 높은 결과를 제공합니다.
제품 설명
King Agar BNutriSelect Basic은 일반적인 미생물 배양에 적합한 고품질 배지로, 다양한 실험 환경에서 일관된 성능을 보장합니다.
제품 스펙
| 항목 | 내용 |
|---|---|
| Size (크기) | 1/G |
| Packaging UOM (포장 단위) | G |
| Number Of Containers Package Unit (포장 단위당 제품 수) | 500G/G |
| Individual Container Size In Package Unit (개별 포장당 용량) | 1/G |
| UNSPSC (UNSPSC 분류) | 41171606 |
| Flash Point (발화점) | Not applicable |
| Merck URL (머크 페이지 주소) | https://www.sigmaaldrich.com/US/en/product/SIAL/60786?context=product |
카탈로그 번호
- 60786-500G
제품 이미지
(이미지 없음)
🏷️Merck Sigma 상품 둘러보기
동일 브랜드의 다른 상품들을 확인해보세요

Merck Sigma
Merck SILICA GEL/TLC CARDS, WITH FLUORESC.IND.
190,400원

Merck Sigma
Merck L-GLUTAMINE-13C5,15N2 98+%13C-98+%15N
4,412,000원

Merck Sigma
Merck King Agar BNutriSelect Basic
279,900원

Merck Sigma
Merck SILICA GEL/TLC-CARDS, WITH FLUORESC.IND.
302,200원

Merck Sigma
Merck SILICA GEL GF(254) FOR TLC WITH CA15%CA&
272,900원
배송/결제/교환/반품 안내
배송 정보
| 기본 배송비 |
| 교환/반품 배송비 |
|
|---|---|---|---|
| 착불 배송비 |
| ||
| 교환/반품 배송비 |
| ||
결제 및 환불 안내
| 결제수단 |
|
|---|---|
| 취소 |
|
| 반품 |
|
| 환급 |
|
교환 및 반품 접수
| 교환 및 반품 접수 기한 |
|
|---|---|
| 교환 및 반품 접수가 가능한 경우 |
|
| 교환 및 반품 접수가 불가능한 경우 |
|
교환 및 반품 신청
| 교환 절차 |
|
|---|---|
| 반품 절차 |
|
문의 0
로그인 후 문의를 할 수 있습니다.